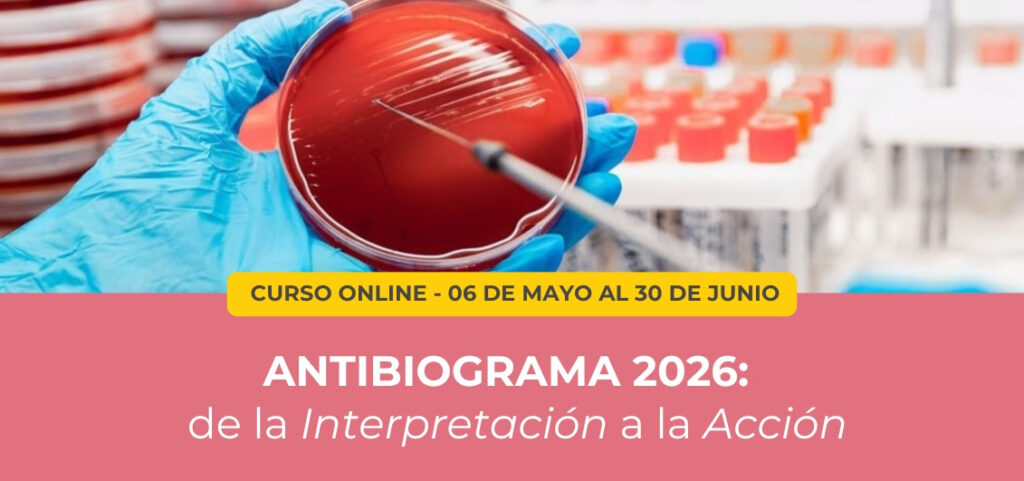

DIRECTOR ACADÉMICO
Dr. Melchor Sánchez Mendiola
Pediatra y educador médico con formación en la Escuela Médico Militar y el Hospital Central Militar. Fue investigador clínico en el Laboratorio de Nutrición Humana y Metabolismo del MIT (Cambridge, EE. UU.). Cuenta con una Maestría en Educación en Ciencias de la Salud por la Universidad de Illinois en Chicago y un Doctorado en Ciencias de la Educación en Ciencias de la Salud por la UNAM. Actualmente es responsable de la Maestría y el Doctorado en Educación en Ciencias de la Salud del Posgrado de la UNAM.

DIRECTORA ACADÉMICA
Dra. Roberta Ladenheim
Médico especialista en Medicina Interna. Magíster en Educación de Profesionales de la Salud. Asesora del Rectorado de la Universidad del Hospital Italiano de Buenos Aires.

COORDINADORA ACADÉMICA
Dra. Analia Baum
Médica especializada en Informática en Salud y máster en Educación para Profesionales de la Salud por el Hospital Italiano de Buenos Aires. Con experiencia en liderazgo y transformación digital en salud. Miembro del HIMSS Americas Board of Advisors y de la International Academy of Health Sciences Informatics (IAHSI), actualmente integra el Departamento de Informática en Salud del HIBA y es docente en diversas instituciones, enfocada en salud digital y alfabetización digital.